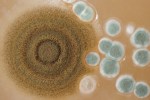
Image: FreeDigitalPhotos.net

witzshared.com
It’s America’s birthday and our Nation is another year older and not too bad looking for a 238 year old. Definitely not the same size and as with most of us has expanded with age to 50 states and still, to this day, these words, “We hold these truths to be self-evident, that all men are created equal, that they are endowed by their Creator with certain unalienable Rights, that among these are Life, Liberty and the pursuit of Happiness.-” are beautiful, elegant yet powerful. Pretty cool words from a bunch of rebellious rabble who took on the task of kicking the mighty Great Britain out of our colonies and lived to tell about it. These alleged rebels, our forefathers; Washington, Jefferson, Adams, and Franklin, blessed with unbelievable foresight and intelligent thought sat down together, debated and discussed and forged a Nation, only made stronger by that magnificent living document, the Constitution which has been the law of the land for 238 years. These words along with their amendments and interpretations are the fabric of the nation and they have been threatened, fought over, fought for, defended, marched on, protested, boycotted, immigrated, renounced and criticized and yet they still offer hope, opportunities, new beginnings and life, liberty and the pursuit of happiness along with Freedom. Freedom to work on the job without fear of dying instantly or dying 20 years from now from a malady. You have the freedom to question your boss and ask for the proper equipment to do the job safely and you have the right to go home the same way you arrived at work, in one piece. Wow, were still talking about people dying on the job, that unfortunately sounds to me like another episode of Companies Behaving Badly.

Middletown carpet company fined for worker’s CO death – PREVENTABLE – Robert Williams a 67 year old, who was a part time worker at Custom Carpets for the last 46 years, was found non-responsive on the floor and later died at the hospital from Carbon Monoxide poisoning. The retired machine operator, (he had worked 2 jobs until he retired from Cytec Industries two years ago) was exposed to 8.85 times the OSHA permissible exposure limit of CO. He had been operating a forklift with the roll up doors down and there was no other proper ventilation of the gas or a CO detector in the area to warn Robert. Another worker had fallen ill as well from the CO and left the premises to seek aid after assuming that Mr. Williams had also left until a truck driver making a delivery found Williams’ body some time later. Custom Carpets was hit with a $12,400 fine. CO gas is colorless and odorless and you should not operate any piece of equipment that produces exhaust in-doors without proper ventilation.
Forklift Fatally Crushes Crushes Brooklyn Worker Against Wall – PREVENTABLE – Gustavo Tapia a 22 year old, just beginning his life and career was killed when a forklift he was pushing up an incline with an electric pallet stacker rolled back and crushed him against a concrete wall. Even though the operator was in the forklift as it was being pushed he couldn’t stop it from rolling back. The article says it was a freak accident but this was an accident due to lack of training and common sense. The load limit for a pallet stacker is about 2200 pounds and was trying to push a forklift up hill that probably weighed about 3000 pounds or more. Physics is not a forgiving science. They had probably been getting away with this unsafe act for quite some time and now a young man has learned the ultimate lesson the hard way, with his life.

Aerojet facing $67,000 in fines for explosion that killed worker in Rancho Cordova – PREVENTABLE – Robert Ortiz a 54 year old employee with 33 years of service at Aerojet under his belt was cutting through solid rocket propellant with a bandsaw when an explosion occurred. Mr. Ortiz succumbed to his injuries 5 months later at UC Davis Medical Center. OSHA found 6 serious violations and 3 less serious for a total of $$66,935 in fines, issues which Aerojet has since corrected. One of the violations was their inadequate training procedures.
OSHA Fines Seafood Company and Temp Agency Following Worker’s Death – PREVENTABLE – It was a cold New England night at Sea Watch International in New Bedford, Ma. when Victor Gerena a 35 year old, well liked by his coworkers and father of several children was killed on the job when he became entangled in shucking machinery he was trying to clean. OSHA found 7 violations with a pending fine of just over $35,000 and to no ones surprise one of the violations was for failing to put in place procedures to quickly switch off dangerous machinery. According to MassCOSH this was not the first time Sea Watch was cited for placing workers in danger. In 2011 OSHA found inadequate emergency training for employees dealing with hazardous waste and insufficient respiratory protection. Isn’t that nice? Even though Victor Gerena was directly employed by Sea Watch, the temp agency Workforce Unlimited which supplies workers was also fined for failing to train workers. You know it cost clams for workplace safety.
OSHA cites two N.J. companies over worker’s injury – PREVENTABLE – Glad to see OSHA is holding temp agencies just as responsible for worker safety. Inspectors came to visit Maplewood Beverage Packers LLC after a temporary worker was injured falling off a ladder. What OSHA found was appalling, willful and repeat violations which accounts for the heavy fine of which Maplewood received the bulk of it. Corporate Resource Services Corp the temp agency was also investigated in conjunction with the Maplewood accident and fined $11,000. Temp agencies who purposely put their workers into a meat grinder so they can collect their fees is nothing more than a human trafficker. A good agency knows their clients needs, assures their placements are properly trained in safety and placed into jobs they can handle along with the proper PPE.

OSHA Issues Fines of $145,000 to Buchman Lumber Co. – PREVENTABLE – What began as an employee complaint turned into a major investigation of Buchman Lumber Co. LLC as it was found they had no problem exposing their workers to excessive noise and amputation hazards, so much so that it resulted in OSHA finding 17 violations, including 4 willful violations for a proposed fine of $145,200. The violations included failure to protect workers from serious hazards of exposure to excessive noise which can lead to permanent, disabling injury. In case you don’t remember, a willful violation basically means the company couldn’t care less what happened to their employees and to sum it all up, some of the serious violations involved failing to develop and train workers in a hazard communication program, electrical safety, PPE and machines with no guarding.
OSHA fines California Cereal Products in Macon – PREVENTABLE – California Cereal Products Inc. is an organic, gluten-free producer of rice flour products but not too organic about exposing workers to electrical, fall and noise hazards as alleged by OSHA. A fine of $39,900 was issued for lack of training to protect permanent and temporary workers from moving machine parts during servicing and maintenance activities and exposing workers to fall hazards. LOTO needs to start being part of a national training standard. They should be no excuse for working on live equipment.
US Department of Labor’s OSHA proposes $449,680 fine for Fontarome Chemical after inspection finds 23 serious safety and health violations – PREVENTABLE – The Fontarome Chemical Inc. of St.Francis, Wis. has landed itself in OSHA’s Severe Violator Enforcement Program. It came easy to them as they were found to have 23 safety and health violations including 7 willful and one repeat bringing the fines to $449,680. They not only didn’t care about what happened to their workers but also failed to protect them from highly hazardous chemicals, failed to establish safe operating procedures, develop safety information for equipment, correct problems or do inspections while failing to protect workers from dangerous machines during maintenance. Workers need to focus on doing their jobs and not dancing around to stay alive.
W.Va. Chemical Spill Company Facing More Violations – PREVENTABLE – Nothing better than a disaster that must keeps on giving. A storm water collection trench overflowed at the same place where chemicals spilled into West Virginia’s largest water supply in January.
Safety Foul-Up Exposes CDC Staff to Anthrax – PREVENTABLE – Procedures are put in place for a specific reason. To ensure you complete the task the best way and safest way. When you cut corners and don’t follow procedure bad things can happen as the CDC will tell you. There are NO short cuts to safety.
Texas Worker Safety Hotline Falters – OOPS – The Safety Violations Hotline Program, a bilingual, 24-hours, toll-free line for employees to report unsafe working conditions was experiencing some issues one night. A recorded message urged callers to call back during regular business hours and wouldn’t allow one to leave a message. Wow, look at that, no calls, everyone must be working safe, NOT.
Europe Takes a Close Look at Safety Concerns Caused by Forklifts & Cost of Forklift Accidents Drive European Companies to Forklift Free Effort – POV – You can read about Europe’s take on how to deal with Forklift accidents and the related costs. Interesting reading.
Glove coatings enhance grip and durability – PRODUCT – Gloves can protect your workers and significantly reduce the number of hand injuries. Check out the new product.
That my friends brings this issue of Companies Behaving badly to a close. Glad you could stop by and check out the latest issue. Your support is always appreciated and please feel free to share these stories at your next safety tailgate/toolbox meeting. Let’s all work together and eliminate the #3 Men’s Killer – Accidents. While preparing for this issue I happened to watch Witney Cummings stand up routine on the Comedy Central Channel. She has done her research and knows men to a T. Yes, she jokes about a general stereotype of men, but I’d dare say that most of us have ventured into pure maleness one time or another in our lives. Don’t do it at work. You’re not a superhero, you are mortal. What you think may save some time could cost you a life time of disability and pain. Don’t let anyone talk you into committing an unsafe act, let them do it. You don’t have to. Until next month, be safe.


Leave a comment